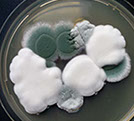

16.12.19
[ Mathématiques, Télécommunications, Réseaux]
Et si nos mobiles servaient également de relais ?
16.12.19
[ Biologie, Lipidologie, Obésité]
28.10.18
[ Alimentation, Agroalimentaire
01.03.18
[ Agronomie/Génétique]
31.10.17
Chimie/Informatique
24.07.17
[ Biomédical ]
21.07.17
[ Micro et Nanoélectronique]
25.04.17
[ Nanothecnologies]
06.03.17
[ Robotique]
23.04.16
[Médecine/Mécanique des fluides/Pneumologie]
04.02.16
[Chimie/Médecine]
01.01.16
[Microbiologie/Médecine]
25.11.15
[Instrumentation]
23.11.15
[ Transports/Énergie]